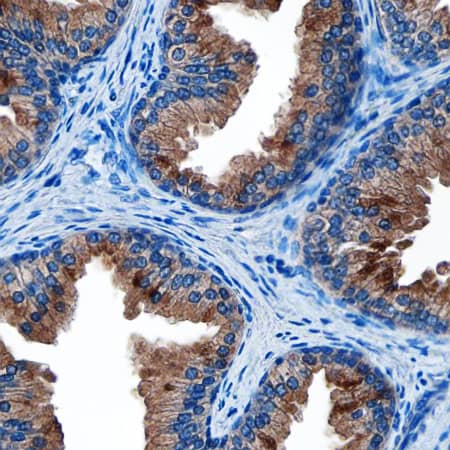
Kallikrein 3/PSA antibody in Prostate Cancer by Immunohistochemistry (IHC-P).

Human Kallikrein 3/PSA Antibody
R&D Systems, part of Bio-Techne | Catalog # MAB1344


Conjugate
Catalog #
Key Product Details
Species Reactivity
Validated:
Human
Cited:
Human
Applications
Validated:
Immunohistochemistry, Western Blot, Immunocytochemistry, Immunoprecipitation
Cited:
ELISA Microarray Development
Label
Unconjugated
Antibody Source
Monoclonal Mouse IgG2B Clone # 181823
Product Specifications
Immunogen
Mouse myeloma cell line NS0-derived recombinant human Kallikrein 3/PSA
Ala18-Pro261
Accession # P07288
Ala18-Pro261
Accession # P07288
Specificity
Detects human Kallikrein 3/PSA in direct ELISAs and Western blots. In direct ELISAs, no cross-reactivity with recombinant human Kallikrein 5 or 11 is observed.
Clonality
Monoclonal
Host
Mouse
Isotype
IgG2B
Scientific Data Images for Human Kallikrein 3/PSA Antibody
Detection of Human Kallikrein 3/PSA by Western Blot.
Western blot shows lysates of human prostate tissue. PVDF membrane was probed with 2 µg/mL of Mouse Anti-Human Kallikrein 3/PSA Monoclonal Antibody (Catalog # MAB1344) followed by HRP-conjugated Anti-Mouse IgG Secondary Antibody (Catalog # HAF018). A specific band was detected for Kallikrein 3/PSA at approximately 30 kDa (as indicated). This experiment was conducted under reducing conditions and using Immunoblot Buffer Group 1.Kallikrein 3/PSA in LNCaP and MCF-7 Human Cell Lines.
Kallikrein 3/PSA was detected in immersion fixed LNCaP human prostate cancer cell line (positive control, left panel) and MCF-7 human breast cancer cell line (negative control, right panel) using Mouse Anti-Human Kallikrein 3/PSA Monoclonal Antibody (Catalog # MAB1344) at 8 µg/mL for 3 hours at room temperature. Cells were stained using the NorthernLights™ 557-conjugated Anti-Mouse IgG Secondary Antibody (red; Catalog # NL007) and counterstained with DAPI (blue). Specific staining was localized to cytoplasm in LNCaP cells. View our protocol for Fluorescent ICC Staining of Cells on Coverslips.Kallikrein 3/PSA in Prostate Cancer.
Kallikrein 3/PSA was detected in immersion fixed paraffin-embedded sections of prostate cancer tissue using Mouse Anti-Human Kallikrein 3/PSA Monoclonal Antibody (Catalog # MAB1344) at 1.7 µg/mL overnight at 4 °C. Tissue was stained using the Anti-Mouse HRP-DAB Cell & Tissue Staining Kit (brown; Catalog # CTS002) and counterstained with hematoxylin (blue). Specific staining was localized to the apical plasma membrane. View our protocol for Chromogenic IHC Staining of Paraffin-embedded Tissue Sections.Applications for Human Kallikrein 3/PSA Antibody
Application
Recommended Usage
Immunocytochemistry
8-25 µg/mL
Sample: Immersion fixed LNCaP human prostate cancer cell line
Sample: Immersion fixed LNCaP human prostate cancer cell line
Immunohistochemistry
8-25 µg/mL
Sample: Immersion fixed paraffin-embedded prostate cancer tissue
Sample: Immersion fixed paraffin-embedded prostate cancer tissue
Immunoprecipitation
25 µg/mL
Sample: Conditioned cell culture medium spiked with Recombinant Human Kallikrein 3/PSA (Catalog # 1344-SE), see our available Western blot detection antibodies
Sample: Conditioned cell culture medium spiked with Recombinant Human Kallikrein 3/PSA (Catalog # 1344-SE), see our available Western blot detection antibodies
Western Blot
2 µg/mL
Sample: Human prostate tissue
Sample: Human prostate tissue
Reviewed Applications
Read 1 review rated 5 using MAB1344 in the following applications:
Formulation, Preparation, and Storage
Purification
Protein A or G purified from hybridoma culture supernatant
Reconstitution
Reconstitute at 0.5 mg/mL in sterile PBS. For liquid material, refer to CoA for concentration.
Formulation
Lyophilized from a 0.2 μm filtered solution in PBS with Trehalose. *Small pack size (SP) is supplied either lyophilized or as a 0.2 µm filtered solution in PBS.
Shipping
Lyophilized product is shipped at ambient temperature. Liquid small pack size (-SP) is shipped with polar packs. Upon receipt, store immediately at the temperature recommended below.
Stability & Storage
Use a manual defrost freezer and avoid repeated freeze-thaw cycles.
- 12 months from date of receipt, -20 to -70 °C as supplied.
- 1 month, 2 to 8 °C under sterile conditions after reconstitution.
- 6 months, -20 to -70 °C under sterile conditions after reconstitution.
Background: Kallikrein 3/PSA
References
- Yousef, G.M. and E.P. Diamandis (2001) Endocrine Rev. 22:184.
- Ward, A.M. et al. (2001) Ann. Clin. Biochem. 38:633.
- Jain, S. et al. (2002) Postgrad. Med. J. 78:646.
- Lilja H. (2003) Urology 62:270.
- Takayama, T.K. et al. (1997) J. Biol. Chem. 272:21582.
Alternate Names
KLK3, PSA
Entrez Gene IDs
354 (Human)
Gene Symbol
KLK3
UniProt
Additional Kallikrein 3/PSA Products
Product Documents for Human Kallikrein 3/PSA Antibody
Product Specific Notices for Human Kallikrein 3/PSA Antibody
For research use only
Loading...
Loading...
Loading...
Loading...